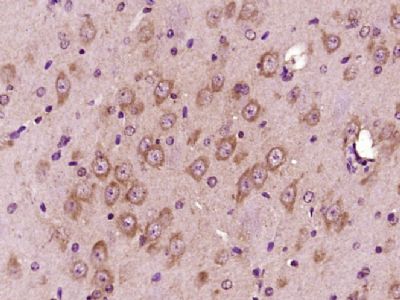
产品封面图

相关产品推荐更多 >
万千商家帮你免费找货
0 人在求购买到急需产品
- 详细信息
- 文献和实验
- 技术资料
- 供应商:
上海康朗生物科技有限公司
- 库存:
大量
- 目录编号:
kl-0877R
- 克隆性:
多克隆
- 抗原来源:
Rabbit
- 保质期:
12个月
- 抗体英文名:
beta-Amyloid 1-40 (CT) antibody
- 抗体名:
β淀粉样肽1-40 C端/Aβ1-40 C端抗体
- 宿主:
Rabbit
- 适应物种:
Human, Mouse, Rat, Chicken, Dog, Pig, Cow, Rabbit,
- 免疫原:
KLH conjugated synthetic peptide derived from human beta-Amyloid 1-40:37-40/40
- 亚型:
IgG
- 形态:
冻干粉或液体
- 应用范围:
ELISA=1:500-1000 IHC-P=1:400-800 IHC-F=1:400-800 Flow-Cyt=0.2μg/Test ICC=1:100-500 IF=1:100-500
- 浓度:
1mg/ml
- 保存条件:
-20 °C
- 规格:
50ul 100ul 200ul
| 中文名称 | β淀粉样肽1-40 C端/Aβ1-40 C端抗体 |
| 别 名 | beta Amyloid(1-40); beta Amyloid 1-40; beta-Amyloid 1-40; Amyloid 1-40; P3(40); A4; AAA; ABETA; ABPP; AD1; Alzheimers Disease Amyloid Protein; Amyloid B; Amyloid Beta A4 Protein Precursor; Amyloid Beta; Amyloid of Aging and Alzheimer Disease; APP; APPI; B Amyloid; Beta APP; Cerebral Vascular Amyloid Peptide; CTFgamma; CVAP; PN II; PN2; PreA4; Protease nexin II; A beta; A4_HUMAN. |
| 规格价格 | 50ul/780元 购买 100ul/1380元 购买 200ul/2200元 购买 大包装/询价 |
| 说 明 书 | 50ul 100ul 200ul |
| 研究领域 | 细胞生物 免疫学 神经生物学 信号转导 细胞凋亡 Alzheimer's |
| 抗体来源 | Rabbit |
| 克隆类型 | Polyclonal |
| 交叉反应 | Human, Mouse, Rat, Chicken, Dog, Pig, Cow, Rabbit, |
| 产品应用 | ELISA=1:500-1000 IHC-P=1:400-800 IHC-F=1:400-800 Flow-Cyt=0.2μg/Test ICC=1:100-500 IF=1:100-500 (石蜡切片需做抗原修复) not yet tested in other applications. optimal dilutions/concentrations should be determined by the end user. |
| 分 子 量 | 4.3kDa |
| 细胞定位 | 细胞浆 细胞膜 细胞外基质 |
| 性 状 | Lyophilized or Liquid |
| 浓 度 | 1mg/ml |
| 免 疫 原 | KLH conjugated synthetic peptide derived from human beta-Amyloid 1-40:37-40/40 |
| 亚 型 | IgG |
| 纯化方法 | affinity purified by Protein A |
| 储 存 液 | 0.01M TBS(pH7.4) with 1% BSA, 0.03% Proclin300 and 50% Glycerol. |
| 保存条件 | Store at -20 °C for one year. Avoid repeated freeze/thaw cycles. The lyophilized antibody is stable at room temperature for at least one month and for greater than a year when kept at -20°C. When reconstituted in sterile pH 7.4 0.01M PBS or diluent of antibody the antibody is stable for at least two weeks at 2-4 °C. |
| PubMed | PubMed |
| 产品介绍 | background: The cerebral and vascular plaques associated with Alzheimer's disease are mainly composed of Amyloid beta peptides. beta Amyloid is derived from cleavage of the Amyloid precursor protein and varies in length from 39 to 43 amino acids. beta Amyloid [1-40], beta Amyloid [1-42], and beta Amyloid [1-43] peptides result from cleavage of Amyloid precursor protein after residues 40, 42, and 43, respectively. The cleavage takes place by gamma-secretase during the last Amyloid precursor protein processing step. beta Amyloid [1-40], beta Amyloid [1-42], and beta Amyloid [1-43] peptides are major constituents of the plaques and tangles that occur in Alzheimer's disease. beta Amyloid antibodies and peptides have been developed as tools for elucidating the biology of Alzheimer's disease. Function: Functions as a cell surface receptor and performs physiological functions on the surface of neurons relevant to neurite growth, neuronal adhesion and axonogenesis. Involved in cell mobility and transcription regulation through protein-protein interactions. Can promote transcription activation through binding to APBB1-KAT5 and inhibits Notch signaling through interaction with Numb. Couples to apoptosis-inducing pathways such as those mediated by G(O) and JIP. Inhibits G(o) alpha ATPase activity. Acts as a kinesin I membrane receptor, mediating the axonal transport of beta-secretase and presenilin 1. Involved in copper homeostasis/oxidative stress through copper ion reduction. In vitro, copper-metallated APP induces neuronal death directly or is potentiated through Cu(2+)-mediated low-density lipoprotein oxidation. Can regulate neurite outgrowth through binding to components of the extracellular matrix such as heparin and collagen I and IV. The splice isoforms that contain the BPTI domain possess protease inhibitor activity. Induces a AGER-dependent pathway that involves activation of p38 MAPK, resulting in internalization of amyloid-beta peptide and leading to mitochondrial dysfunction in cultured cortical neurons. Beta-amyloid peptides are lipophilic metal chelators with metal-reducing activity. Bind transient metals such as copper, zinc and iron. In vitro, can reduce Cu(2+) and Fe(3+) to Cu(+) and Fe(2+), respectively. Beta-amyloid 42 is a more effective reductant than beta-amyloid 40. Beta-amyloid peptides bind to lipoproteins and apolipoproteins E and J in the CSF and to HDL particles in plasma, inhibiting metal-catalyzed oxidation of lipoproteins. Beta-APP42 may activate mononuclear phagocytes in the brain and elicit inflammatory responses. Promotes both tau aggregation and TPK II-mediated phosphorylation. Interaction with overexpressed HADH2 leads to oxidative stress and neurotoxicity. Appicans elicit adhesion of neural cells to the extracellular matrix and may regulate neurite outgrowth in the brai. The gamma-CTF peptides as well as the caspase-cleaved peptides, including C31, are potent enhancers of neuronal apoptosis. N-APP binds TNFRSF21 triggering caspase activation and degeneration of both neuronal cell bodies (via caspase-3) and axons (via caspase-6). Subunit: Binds, via its C-terminus, to the PID domain of several cytoplasmic proteins, including APBB family members, the APBA family, MAPK8IP1, SHC1 and, NUMB and DAB. Binding to DAB1 inhibits its serine phosphorylation (By similarity). Also interacts with GPCR-like protein BPP, FPRL1, APPBP1, IB1, KNS2 (via its TPR domains), APPBP2 (via BaSS) and DDB1. In vitro, it binds MAPT via the MT-binding domains. Associates with microtubules in the presence of ATP and in a kinesin-dependent manner. Interacts, through a C-terminal domain, with GNAO1. Amyloid beta-42 binds CHRNA7 in hippocampal neurons. Beta-amyloid associates with HADH2. Soluble APP binds, via its N-terminal head, to FBLN1. Interacts with CPEB1 and AGER. Interacts with ANKS1B and TNFRSF21. Interacts with ITM2B. Interacts with ITM2C. Interacts with IDE. Can form homodimers; this is promoted by heparin binding. Subcellular Location: Membrane; Single-pass type I membrane protein. Membrane, clathrin-coated pit. Note=Cell surface protein that rapidly becomes internalized via clathrin-coated pits. During maturation, the immature APP (N-glycosylated in the endoplasmic reticulum) moves to the Golgi complex where complete maturation occurs (O-glycosylated and sulfated). After alpha-secretase cleavage, soluble APP is released into the extracellular space and the C-terminal is internalized to endosomes and lysosomes. Some APP accumulates in secretory transport vesicles leaving the late Golgi compartment and returns to the cell surface. Gamma-CTF(59) peptide is located to both the cytoplasm and nuclei of neurons. It can be translocated to the nucleus through association with APBB1 (Fe65). Beta-APP42 associates with FRPL1 at the cell surface and the complex is then rapidly internalized. APP sorts to the basolateral surface in epithelial cells. During neuronal differentiation, the Thr-743 phosphorylated form is located mainly in growth cones, moderately in neurites and sparingly in the cell body. Casein kinase phosphorylation can occur either at the cell surface or within a post-Golgi compartment. Tissue Specificity: Expressed in all fetal tissues examined with highest levels in brain, kidney, heart and spleen. Weak expression in liver. In adult brain, highest expression found in the frontal lobe of the cortex and in the anterior perisylvian cortex-opercular gyri. Moderate expression in the cerebellar cortex, the posterior perisylvian cortex-opercular gyri and the temporal associated cortex. Weak expression found in the striate, extra-striate and motor cortices. Expressed in cerebrospinal fluid, and plasma. Isoform APP695 is the predominant form in neuronal tissue, isoform APP751 and isoform APP770 are widely expressed in non-neuronal cells. Isoform APP751 is the most abundant form in T-lymphocytes. Appican is expressed in astrocytes. Post-translational modifications: Proteolytically processed under normal cellular conditions. Cleavage either by alpha-secretase, beta-secretase or theta-secretase leads to generation and extracellular release of soluble APP peptides, S-APP-alpha and S-APP-beta, and the retention of corresponding membrane-anchored C-terminal fragments, C80, C83 and C99. Subsequent processing of C80 and C83 by gamma-secretase yields P3 peptides. This is the major secretory pathway and is non-amyloidogenic. Alternatively, presenilin/nicastrin-mediated gamma-secretase processing of C99 releases the amyloid beta proteins, amyloid-beta 40 (Abeta40) and amyloid-beta 42 (Abeta42), major components of amyloid plaques, and the cytotoxic C-terminal fragments, gamma-CTF(50), gamma-CTF(57) and gamma-CTF(59). Proteolytically cleaved by caspases during neuronal apoptosis. Cleavage at Asp-739 by either caspase-6, -8 or -9 results in the production of the neurotoxic C31 peptide and the increased production of beta-amyloid peptides. N- and O-glycosylated. O-linkage of chondroitin sulfate to the L-APP isoforms produces the APP proteoglycan core proteins, the appicans. The chondroitin sulfate chain of appicans contains 4-O-sulfated galactose in the linkage region and chondroitin sulfate E in the repeated disaccharide region. Phosphorylation in the C-terminal on tyrosine, threonine and serine residues is neuron-specific. Phosphorylation can affect APP processing, neuronal differentiation and interaction with other proteins. Phosphorylated on Thr-743 in neuronal cells by Cdc5 kinase and Mapk10, in dividing cells by Cdc2 kinase in a cell-cycle dependent manner with maximal levels at the G2/M phase and, in vitro, by GSK-3-beta. The Thr-743 phosphorylated form causes a conformational change which reduces binding of Fe65 family members. Phosphorylation on Tyr-757 is required for SHC binding. Phosphorylated in the extracellular domain by casein kinases on both soluble and membrane-bound APP. This phosphorylation is inhibited by heparin. Extracellular binding and reduction of copper, results in a corresponding oxidation of Cys-144 and Cys-158, and the formation of a disulfide bond. In vitro, the APP-Cu(+) complex in the presence of hydrogen peroxide results in an increased production of beta-amyloid-containing peptides. Trophic-factor deprivation triggers the cleavage of surface APP by beta-secretase to release sAPP-beta which is further cleaved to release an N-terminal fragment of APP (N-APP). Beta-amyloid peptides are degraded by IDE. DISEASE: Defects in APP are the cause of Alzheimer disease type 1 (AD1) [MIM:104300]. AD1 is a familial early-onset form of Alzheimer disease. It can be associated with cerebral amyloid angiopathy. Alzheimer disease is a neurodegenerative disorder characterized by progressive dementia, loss of cognitive abilities, and deposition of fibrillar amyloid proteins as intraneuronal neurofibrillary tangles, extracellular amyloid plaques and vascular amyloid deposits. The major constituent of these plaques is the neurotoxic amyloid-beta-APP 40-42 peptide (s), derived proteolytically from the transmembrane precursor protein APP by sequential secretase processing. The cytotoxic C-terminal fragments (CTFs) and the caspase-cleaved products such as C31 derived from APP, are also implicated in neuronal death. Defects in APP are the cause of cerebral amyloid angiopathy APP-related (CAA-APP) [MIM:605714]. A hereditary localized amyloidosis due to amyloid-beta A4 peptide(s) deposition in the cerebral vessels. The principal clinical characteristics are recurrent cerebral and cerebellar hemorrhages, recurrent strokes, cerebral ischemia, cerebral infarction, and progressive mental deterioration. Patients develop cerebral hemorrhage because of the severe cerebral amyloid angiopathy. Parenchymal amyloid deposits are rare and largely in the form of pre-amyloid lesions or diffuse plaque-like structures. They are Congo red negative and lack the dense amyloid cores commonly present in Alzheimer disease. Some affected individuals manifest progressive aphasic dementia, leukoencephalopathy, and occipital calcifications. Similarity: Belongs to the APP family. Contains 1 BPTI/Kunitz inhibitor domain. SWISS: P05067 Gene ID: 351 Database links: Entrez Gene: 351 Human Entrez Gene: 11820 Mouse Entrez Gene: 54226 Rat Omim: 104760 Human SwissProt: P05067 Human SwissProt: P12023 Mouse SwissProt: P08592 Rat Unigene: 434980 Human Unigene: 277585 Mouse Unigene: 2104 Rat Important Note: This product as supplied is intended for research use only, not for use in human, therapeutic or diagnostic applications. β-Amyloid 也称βA4 蛋白,是β-淀粉样蛋白前体(APP)经β和γ分泌酶分解后的产物,有39-43个氨基酸残基组成。是淀粉样蛋白的主要成分。 β-淀粉样蛋白来自β-淀粉样蛋白原,在脑组织的细胞外呈丝状蛋白样沉积 ,是淀粉样结节性神经炎病变的主要蛋白成分,在神经纤维中也有沉积。 |
| 产品图片 | ![]() Paraformaldehyde-fixed, paraffin embedded (Mouse brain); Antigen retrieval by boiling in sodium citrate buffer (pH6.0) for 15min; Block endogenous peroxidase by 3% hydrogen peroxide for 20 minutes; Blocking buffer (normal goat serum) at 37°C for 30min; Antibody incubation with (beta-Amyloid 1-40 (CT)) Polyclonal Antibody, Unconjugated (bs-0877R) at 1:400 overnight at 4°C, followed by operating according to SP Kit(Rabbit) (sp-0023) instructionsand DAB staining. |
风险提示:丁香通仅作为第三方平台,为商家信息发布提供平台空间。用户咨询产品时请注意保护个人信息及财产安全,合理判断,谨慎选购商品,商家和用户对交易行为负责。对于医疗器械类产品,请先查证核实企业经营资质和医疗器械产品注册证情况。
文献和实验上海西唐生物科技有限公司 021-55229872, 65333639 www.westang.com 人心肌营养素-1 (CT-1)ELISA 试剂盒 ( 用于血清、血浆、细胞培养上清液和其它生物体液内 ) 原理 本实验采用双抗体夹心 ABC-ELISA 法。用抗人 CT-1( Cardiotrophin-1 ) 单抗包被于酶标板上,标准品和样品中的 CT-1与单抗结合,加入
上海西唐生物科技有限公司 021-55229872, 65333639 www.westang.com 大鼠心肌营养素 -1(CT-1)ELISA 试剂盒 ( 用于血清、血浆、细胞培养上清液和其它生物体液内 ) 原理 本实验采用双抗体夹心 ABC-ELISA 法。用抗大鼠 CT-1(Cardiotrophin-1 ) 单抗包被于酶标板上,标准品和样品中的 CT-1 与单抗结合,加入生物素化的抗大
Early development of primary motor neurons and somites in Zebrafish Embryos
into three large columns according to their target. Motor neurons in the column of Terni (CT) project into the sympathetic ganglia,those in the lateral motor column (LMC) extend to the limb musculature,and those of the medial motor columns (MMC) project
技术资料暂无技术资料 索取技术资料